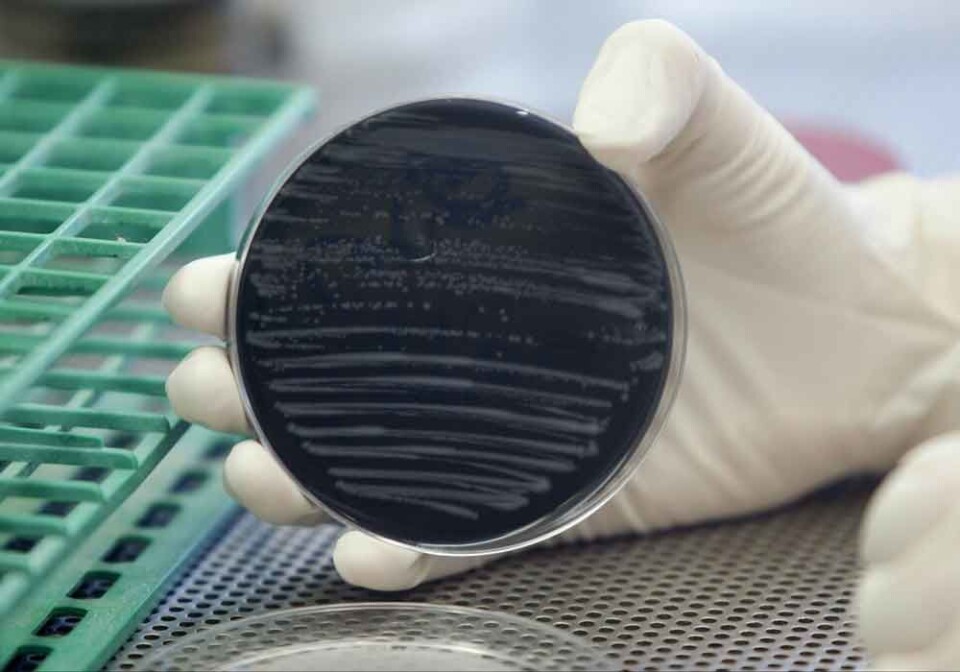

LØNN OG TARIFF
Siste nytt fra hmsmagasinet.no:
-

Gjennombrudd for bærekraftig flammehemming
-

– Digitalisering svekker HMS-forståelsen
-

NHO: Nei til VM i fravær
-

Grisebonde hedret for god HMS
-

Må dele voldshistorikk for å beskytte arbeidsmiljøet
-

Markedet for bedriftshelsetjenester har endret seg
-

Alle tiltalte frikjent etter dødelig byggheisulykke
-

Akan: HMS-pris for nattlig VM-fest
-

Myten om seniorenes manglende læreevne
-

Enighet på Stortinget om nye regler for yrkesskadeerstatning
Siste nytt fra hrmagasinet.no:
-

Høyre vil ha mer hemmelighold rundt jobbsøkere
-
Enighet i lønnsoppgjøret for titusener innen helse, utdanning og kultur
-
Færre flyktninger deltok i introduksjonsprogrammet
-
Stabile sosialhjelp-tall: – Fortsatt på et høyt nivå
-

Tangen skrøt av stor KI-effekt på produktiviteten: – Mer en ambisjon, sier nestsjefen
-

Vedum tror sykehusmodellen ryker snart: – Vi angriper den som juling
-

Kommunene må trene på krig – alle regioner får egne øvelser
-
Ungdoms legebesøk falt med 20 prosent etter nye fraværsregler
-
BI-master på internasjonal toppliste
-
NRK åpner for sluttpakker
-

Vy har brukt 1,6 milliarder på buss for tog siden 2019
-
Ingen KI-jobbkrise i Norge
-

Stadig flere nordmenn unngår nyheter
-

Undersøkelse: Forskuttering av sykepenger kan legge ned 3 av 10 bedrifter: – Ikke til å leve med
-

– Styrene bommer på det viktigste
-

KI-kompetanse er attraktivt, men behovet for ansatte i IT-bransjen faller
-

Akan: Nattlige VM-kamper og bakrus kan få konsekvenser for arbeidslivet
-
Spekter og Legeforeningen enige i sykehusoppgjøret
-
Parat og Virke enige om ny avtale for ansatte i begravelsesbyråer
-
NHOs medlemsundersøkelse: Mest pessimistiske på over to år